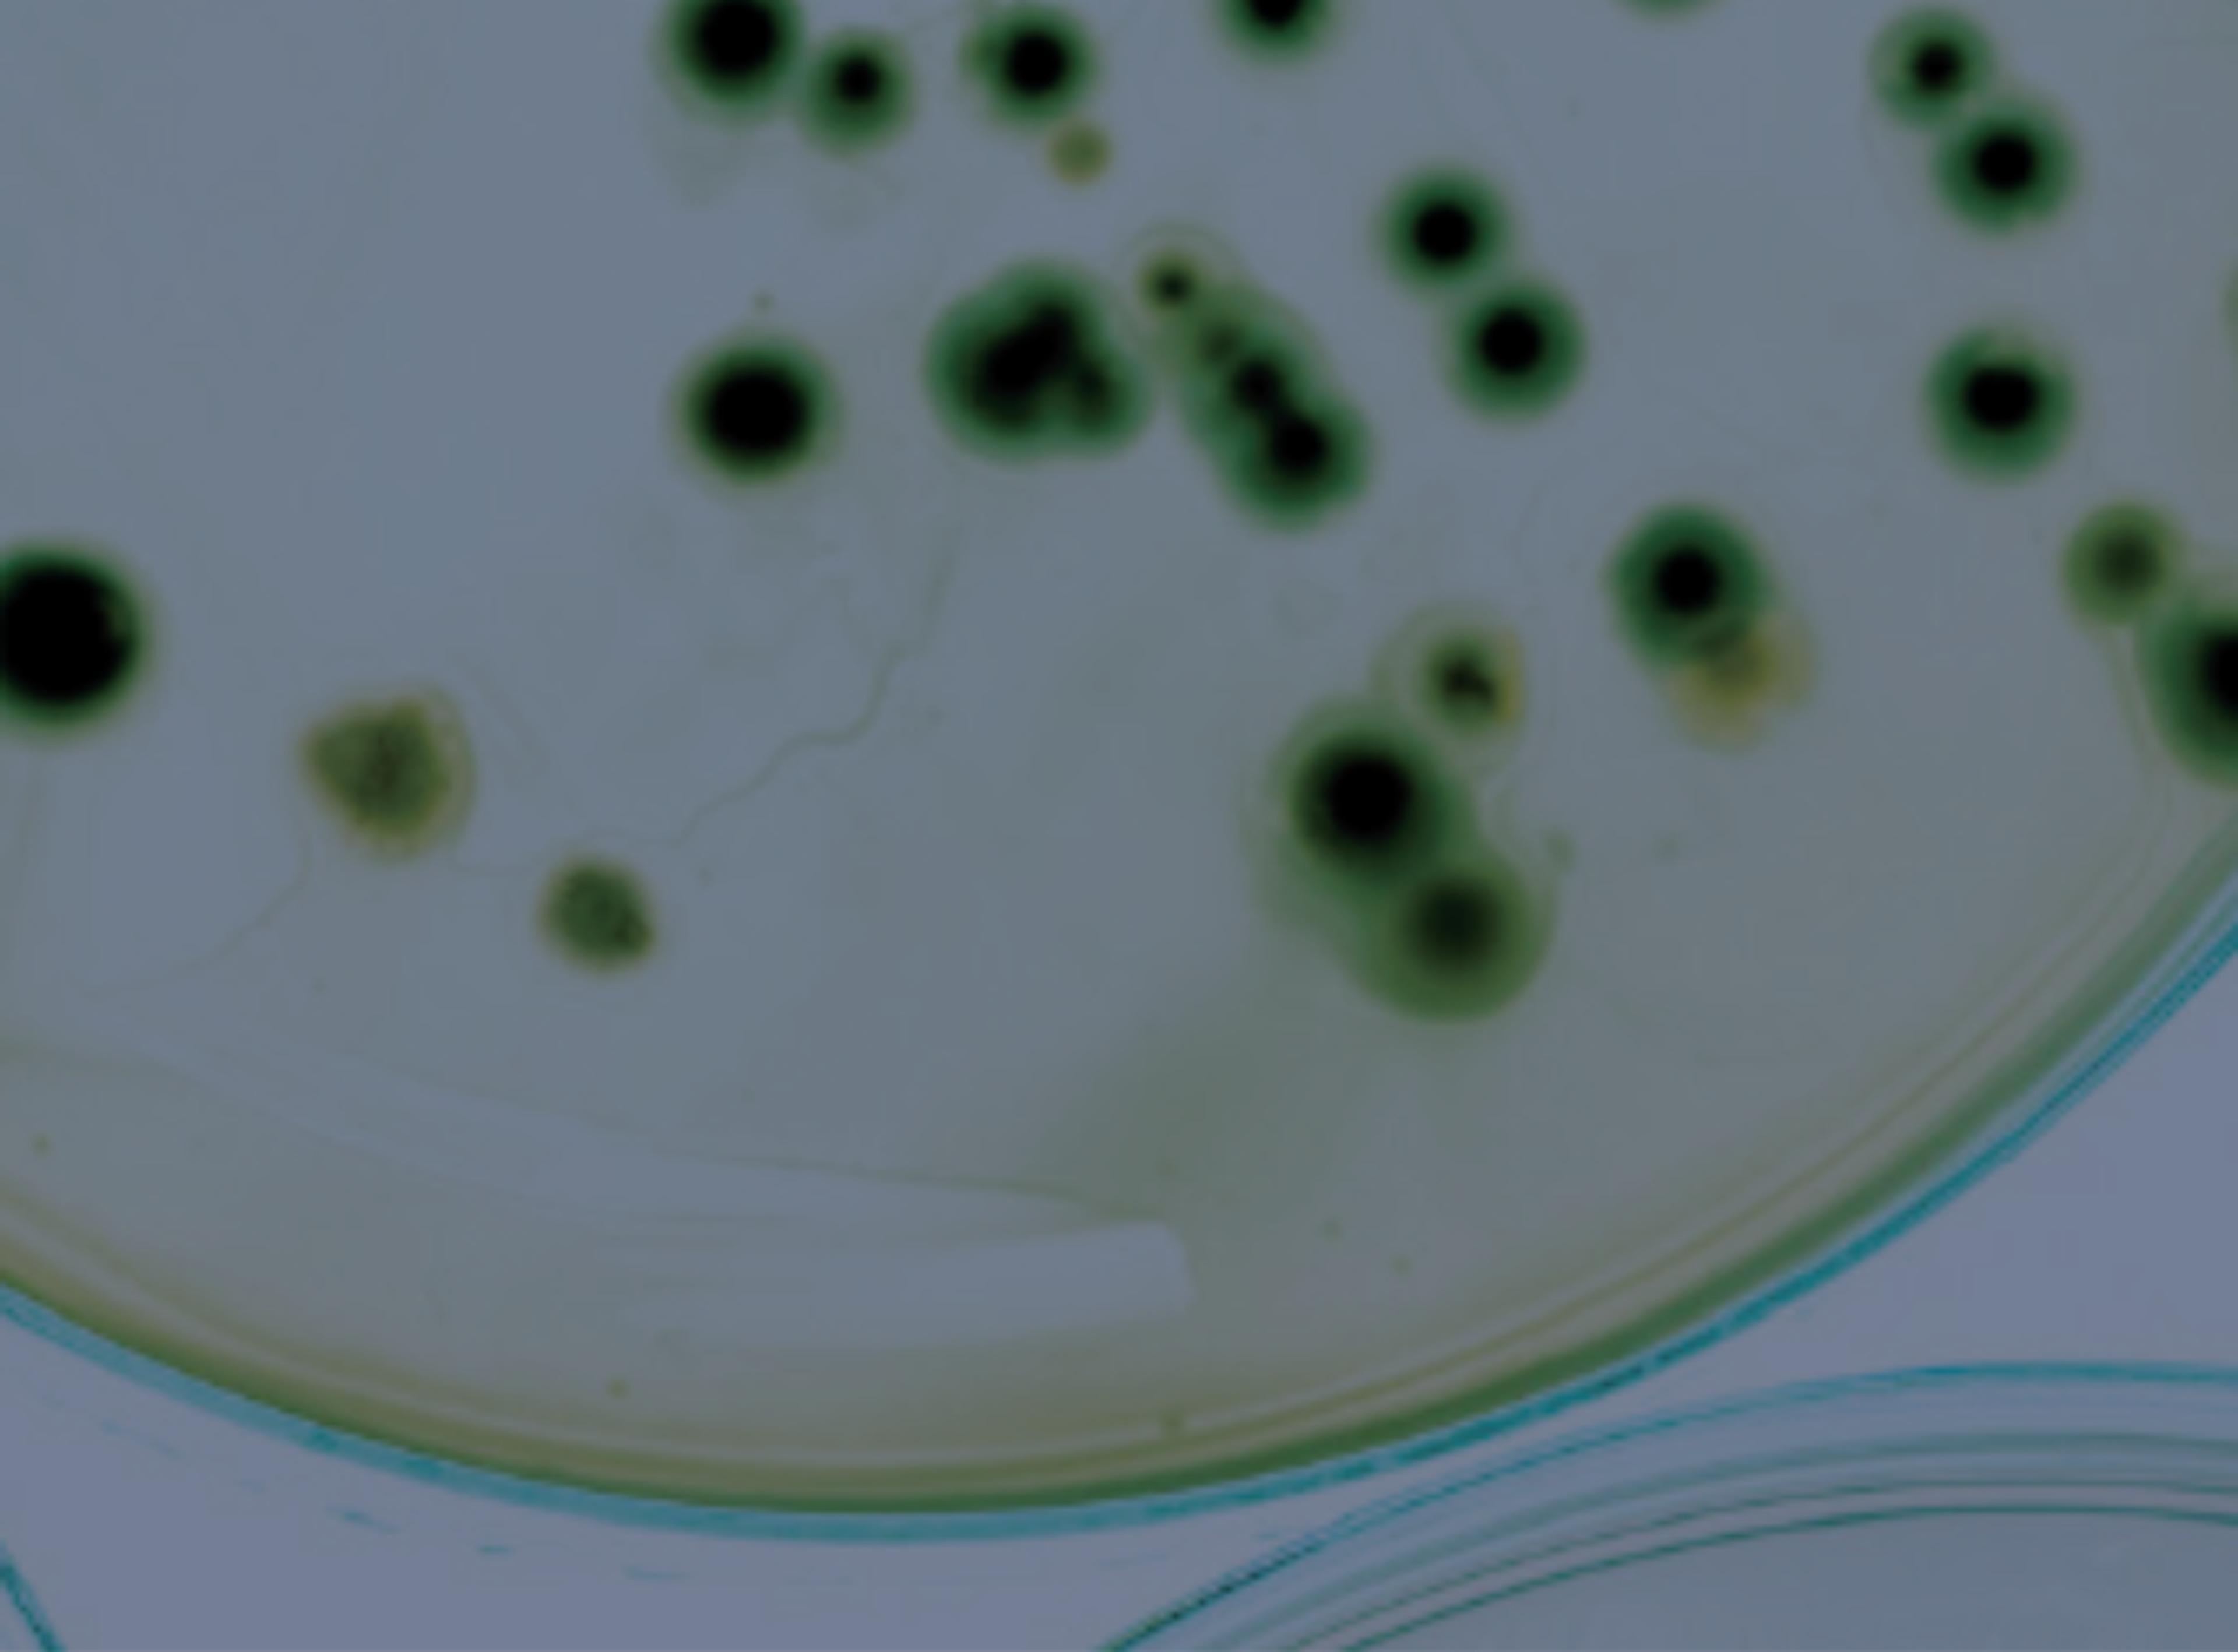

QuickMIC®: Ultra-rapid antibiotic susceptibility testing
QuickMIC is an ultra-rapid AST system, providing precise MIC values directly from positive blood cultures in 2-4 hours.

The supplier does not provide quotations for this product through SelectScience. You can search for similar products in our Product Directory.
QuickMIC Instrument
The QuickMIC instrument can analyse one positive blood culture sample per run, providing precise MIC values in 2–4 hours. The system’s unique technology utilises microfluidics and live imaging to monitor bacterial growth across a linear antibiotic gradient. The small, modular instruments can be stacked to increase testing capacity and save valuable bench space.
QuickMIC Cassette
The QuickMIC cassettes are pre-filled with a panel containing 12 antibiotics, tailored for common sepsis-causing bacteria.
QuickMIC GN panel
The gram-negative panel is tailored for the following bacteria: E. coli, Klebsiella spp., P. aeruginosa, E. cloacae, A. baumannii, Proteus spp., Citrobacter spp. and S. marcescens.
QuickMIC Analyst
The QuickMIC Analyst software analyses the growth patterns of each microcolony along the linear antibiotic gradient to determine precise MIC values.
- The linear gradients offer high precision and reproducibility compared with traditional AST methods.
- Each chamber forms an independent continuous gradient, which can be monitored in real time during the run.
- QuickMIC Analyst supports up to 12 instruments at once.
QuickMIC Workflow
Simply load the cassette with the growth medium and with your gel-embedded sample. Insert it into an available instrument, click “Start Run” and you’re all set.
Brochures
Precise antibiotic guidance in record time with QuickMIC
Gradientech’s QuickMIC® is an ultra-rapid phenotypic antibiotic susceptibility testing (AST) system that delivers precise MIC values from positive blood cultures in just 2–4 hours. Designed to improve sepsis outcomes, it enables same-shift treatment decisions, reduces broad-spectrum antibiotic use, and supports antimicrobial stewardship. Modular, scalable, and highly precise, learn how QuickMIC can transform lab workflows.
Redefining rapid AST for Gram-negative bloodstream infections
Increasing antimicrobial resistance underscores the need for new diagnostic solutions to guide therapy, but traditional antimicrobial susceptibility testing (AST) is often inadequate in time-critical diseases such as sepsis. Despite advances in AST, the delays associated with standard of care tests can lead to suboptimal patient outcomes, increased length of hospital stays, and prolonged exposure to broad-spectrum antibiotics. Common phenotypic methods for AST of bacteria are slow, labor intensive, and display considerable technical variability. In this product brochure, Gradientech describes how the QuickMIC® system provides ultra-rapid AST using a linear concentration gradient of antibiotics, providing precise and accurate MIC values.
Rapid AST for patients with suspected urosepsis: Optimized sample management to reduce time to guide antibiotic therapy
Rapid antimicrobial susceptibility testing (AST) methods are increasingly being adopted to reduce time to guided antibiotic treatment in critically ill patients. This poster presents a study comparing turnaround time of rapid AST for urine culture isolates and positive blood cultures using the QuickMIC rapid AST system and laboratory standard methods. Learn how rapid AST results for patients with suspected sepsis can potentially be achieved faster from urine culture isolates compared to positive blood cultures.
Addressing the roadblocks to rapid AST as the clinical standard
Rapid antimicrobial susceptibility testing (AST) is redefining how clinical microbiology tackles antimicrobial resistance. But while the technology is advancing fast, adoption still varies widely across labs.
An industry-wide survey reveals the landscape of rapid AST implementation, key barriers, and what labs need to move forward.
Key takeaways:
- Innovation is a priority in clinical microbiology, with most labs actively evaluating new tools
- Ultra-rapid AST is delivering measurable benefits in sepsis management and time-to-result
- Manufacturers are driving progress, but labs need clearer pathways to adoption
- Cost, workflow integration, and evidence remain key barriers—but they’re not insurmountable
- There’s strong demand for faster, more precise, and scalable solutions
Whether you're actively evaluating options or weighing the investment, this infographic breaks down the current landscape, top challenges, and what’s needed for successful adoption.
Rapid phenotypic AST for Gram-negative bacteria
Discover the QuickMIC® system’s rapid phenotypic AST capabilities for Gram-negative bacteria, providing highly accurate antibiotic susceptibility results within just 2–4 hours — cutting traditional turnaround times by over 80%. Explore QuickMIC’s significant clinical impact on early infection management, especially in sepsis cases, and its critical role in combating multidrug resistance.
Precision-guided antibiotic treatment for improved sepsis patient management
The adoption of precision-guided antibiotic treatment for sepsis can improve patient outcomes by providing the right therapy at the right time. It relies on rapid diagnostics, real-time patient monitoring, and advanced PK/PD modelling. Implementing these approaches requires collaboration among healthcare professionals and a willingness to move beyond traditional, standardized treatment protocols. Gradientech emphasizes the need for a paradigm shift in sepsis management, advocating for the use of precision-guided treatments supported by cutting-edge diagnostic technologies to reduce mortality and healthcare costs associated with sepsis.
Next-generation antimicrobial susceptibility testing: What’s delaying the revolution?
This eBook highlights current clinical barriers that any emerging next-generation antimicrobial susceptibility testing (AST) solution may face and provides possible solutions to overcoming these challenges.
Rapid AST in sepsis management: Global perspectives on innovation and implementation
April 22, 2025, 15:00 BST / 16:00 CEST / 10:00 EDT / 07:00 PDT
Sepsis and bloodstream infections (BSIs) remain among the most urgent medical emergencies, requiring rapid intervention. The rising threat of antimicrobial resistance (AMR) further complicates treatment, particularly in regions with high resistance rates. Innovative diagnostic tools are critical to improving patient outcomes and combating the spread of resistance.
Rapid antimicrobial susceptibility testing (AST) systems, like the ultra-rapid QuickMIC® system, are revolutionizing infection management by providing clinically actionable MIC values within hours instead of days. These solutions empower clinicians to swiftly tailor antibiotic therapy, curb resistance selection, and enhance the clinical care of critically ill patients.
In this webinar, expert speakers from different AMR landscapes will share their insights and real-world experiences with rapid AST in sepsis management. Join us for a discussion on how rapid AST solutions are transforming laboratory workflows, supporting antimicrobial stewardship, and shaping the future of infection diagnostics.
Key learning objectives:
- Learn about emerging technologies within rapid antimicrobial susceptibility testing (AST) and their value to clinical microbiology labs
- Gain an understanding of how rapid AST methods are used to combat sepsis and antimicrobial resistance in different settings
- Explore real-world applications of rapid AST and examine its impact on laboratory workflows and patient care
Who should attend?
- Microbiologists
- Infectious disease clinicians
- Professionals working within clinical microbiology
Certificate of attendance
All webinar participants can request a certificate of attendance, including a learning outcomes summary, for continuing education purposes.
If you view the on-demand webinar, you can request a certificate of attendance by emailing editor@selectscience.net.
Rapid antimicrobial susceptibility testing could improve outcomes in septic and intensive care patients
Dr. Giuliana Lo Cascio, Medical Doctor and Director of the Unit for Microbiology and Virology at Ospedale Gugliemo da Saliceto di Piacenza, emphasizes the transformative impact of rapid antimicrobial susceptibility testing (AST) in clinical microbiology. By reducing turnaround time to 24 hours or less, this technology enables more targeted and effective treatment for septic and intensive care patients, optimizing therapy and improving patient outcomes.
Beyond patient care, rapid AST reshapes laboratory workflows, requiring strategic integration at both unit and hospital levels. However, adoption faces hurdles, including cost, technician training, and technical constraints in labs without 24-hour operations. Dr. Lo Cascio remains optimistic that, like molecular biology testing, costs will decrease with widespread use.
Collaboration between clinicians, microbiologists, hospital directors, and antimicrobial stewardship teams is essential to overcoming these challenges. By integrating new technologies effectively, hospitals can strengthen their fight against antimicrobial resistance and improve mortality rates.
This video was filmed at ESCMID Global 2025 in Vienna, Austria.
Transforming patient care with ultra-rapid antimicrobial susceptibility testing
Many current antimicrobial susceptibility testing (AST) technologies can bear fundamental limitations, including low speed, high variability, and poor access to methods close to the patient. In this video, Prof. Holger Rohde from the Institute of Medical Microbiology, Virology and Hygiene, Universitätsklinikum Hamburg-Eppendorf, discusses how he uses the QuickMIC® from Gradientech to completely optimize laboratory diagnostic workflows and improve the communication of results to the clinician. Dr. Christer Malmberg, Chief Scientist at Gradientech, explains how this ultra-rapid AST system is designed to enable optimized AST to speed up time to result and delivery of optimized therapy for patients with infectious diseases.
This video was filmed at ECCMID 2023, Copenhagen.
QuickMIC proven 75% faster in sepsis diagnostics in a global multicenter study
The system’s unique technology utilizes microfluidics and live imaging to monitor bacterial growth across a linear antibiotic gradient
Laboratory leaders are turning to rapid AST to advance antimicrobial stewardship
With antimicrobial resistance on the rise, rapid AST offers a lifeline for critically ill patients and supports improved antibiotic stewardship
Gradientech wins Clinical Diagnostics Campaign of the Year
The award recognises Gradientech’s impactful and innovative campaign to raise awareness about its QuickMIC ultra-rapid antibiotic susceptibility testing (AST) system
Gradientech distributor a.d.a. wins tenders for QuickMIC at two important Italian hospitals
QuickMIC systems have already been installed at both hospitals and are now in the process of being implemented in clinical routine
Gradientech at ESCMID Global 2025
Gradientech showcases new QuickMIC clinical data and innovations at ESCMID Global 2025